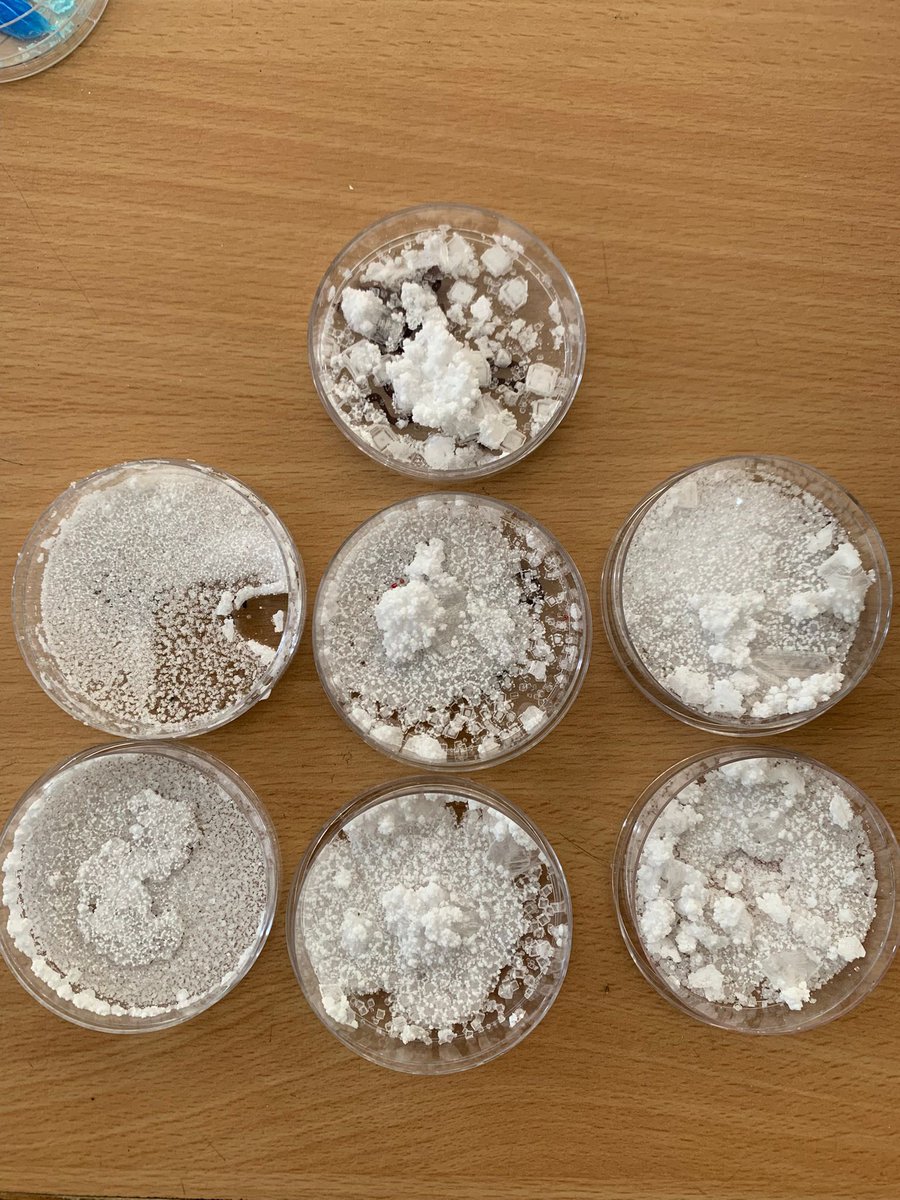
ForresScience's tweet image. Look at the fabulous crystals grown by 1N1 (now 2N1) in Science over the last few weeks from saturated solutions 🌟 @forresacademy1

Dit vind je misschien leuk
We have had fantastic attendances for our Study Support webinars which started this week with almost 4000 learners attending & contributing in the 50+ live online sessions. Have a look on our website at what's coming up next week e-sgoil.com/senior-phase/s… #NeLO #StudySupport

Back to school worries? We have tips & advice to help calm any nerves about going back to school as well as tips for supporting your child’s mental health 💟 ➡️parentclub.scot/articles/help-… #ScotlandParents #BackToSchool

Look at the fabulous crystals grown by 1N1 (now 2N1) in Science over the last few weeks from saturated solutions 🌟 @forresacademy1

S5/6 pupils, are you planning to spend the Easter break revising Higher or Higher Human biology? Sign up to attend our free LabCamp: PCR Masterclass and give yourself a head start on PCR and mutations. More info and sign up edin.ac/4ivp51B Closing date March 27 at 5pm.

Look out for registration going live next week for our Easter Study Support programme. This years programme of live daytime webinars will run from 7-11 April and covers 57 subjects across N4-Advanced Higher. e-sgoil.com/senior-phase/e… #StudySupport #SeniorPhase #NeLO

📣Calling all current S5 pupils who are interested in careers in biological, biomedical or animal sciences. Applications are now open for Science Insights 2025. More info: edin.ac/4ieftb9 To join info session: ed-ac-uk.zoom.us/j/81139220444 Passcode: 7N2XVmrE

First morning of Space Camp. Looking at orbits and satellites. So far, we have researched earth monitoring satellites and the different orbits used. @ForresAcademyHT @UKSpaceAcademy




Good luck to all our seniors opening their envelopes tomorrow! (Or opening texts if they signed up to MySQA 📱) We're proud of how hard you worked and have everything crossed for you 🤞
The Results Helpline opens tomorrow from 8am with a team of expert career advisers waiting to speak to young people or to parents and carers. We can help you understand your results and discuss possible next steps. #SQAResults #ResultsHelpline #Education

Miss McCormick sharing info about our unique setting @forresacademy1 while attending this CPD #LifelongLearners
Leadership in STEM cohort 2 up and running and getting to know one another

A great opportunity for our @forresacademy1 📸 pupils or anyone with an interest 🦋🪲🌱🍄🪻🐝
Leadership in STEM cohort 2 up and running and getting to know one another

A huge thank you to @ForresRotary for funding which allowed us to purchase new kit to support this.
2023 Bronze expedition ✅. A huge well done to all participants. So proud of you all. 👏🏻 🏕




Good luck to our Physicists today who are sitting their exams 🍀
Good Luck 🍀 to all our Chemists sitting their exams today.
Good luck to our Senior Biologists today 🍀🤞🏻 If in doubt, think “What would David do?”
First session with Rachel from @ssencommunity learning about Civil Engineering and building towers @SmartSTEMs @UHIMoray “Nothing is impossible”




3FChem doing #microscale testing of indicators this morning #ActiveLearning #TheForresWay

Our #SCQFAmbassadors enjoyed meeting with others in Moray today to hear what schools are doing, network and make future plans. Thank you @mrs_bayliss for organising

Come and join our team in a beautiful part of the country 🌊🌳🏔️ Teacher of Physics - Forres Academy (August start) - | Moray Council | myjobscotland myjobscotland.gov.uk/councils/moray… # via @myjobscotland
United States Trends
- 1. Panthers 48.3K posts
- 2. Rams 31.9K posts
- 3. Vikings 20.3K posts
- 4. Ole Miss 100K posts
- 5. Colts 33K posts
- 6. Bills 74.6K posts
- 7. Falcons 13.5K posts
- 8. Jets 38.3K posts
- 9. Browns 45.2K posts
- 10. Texans 24.5K posts
- 11. #KeepPounding 9,449 posts
- 12. Brosmer 6,836 posts
- 13. Joe Brady 1,398 posts
- 14. Herbert 6,975 posts
- 15. Seahawks 17.2K posts
- 16. Stafford 20.1K posts
- 17. #Skol 2,283 posts
- 18. Bryce Young 11.8K posts
- 19. Dallas Turner N/A
- 20. Lane 188K posts
Dit vind je misschien leuk
Something went wrong.
Something went wrong.




























































































